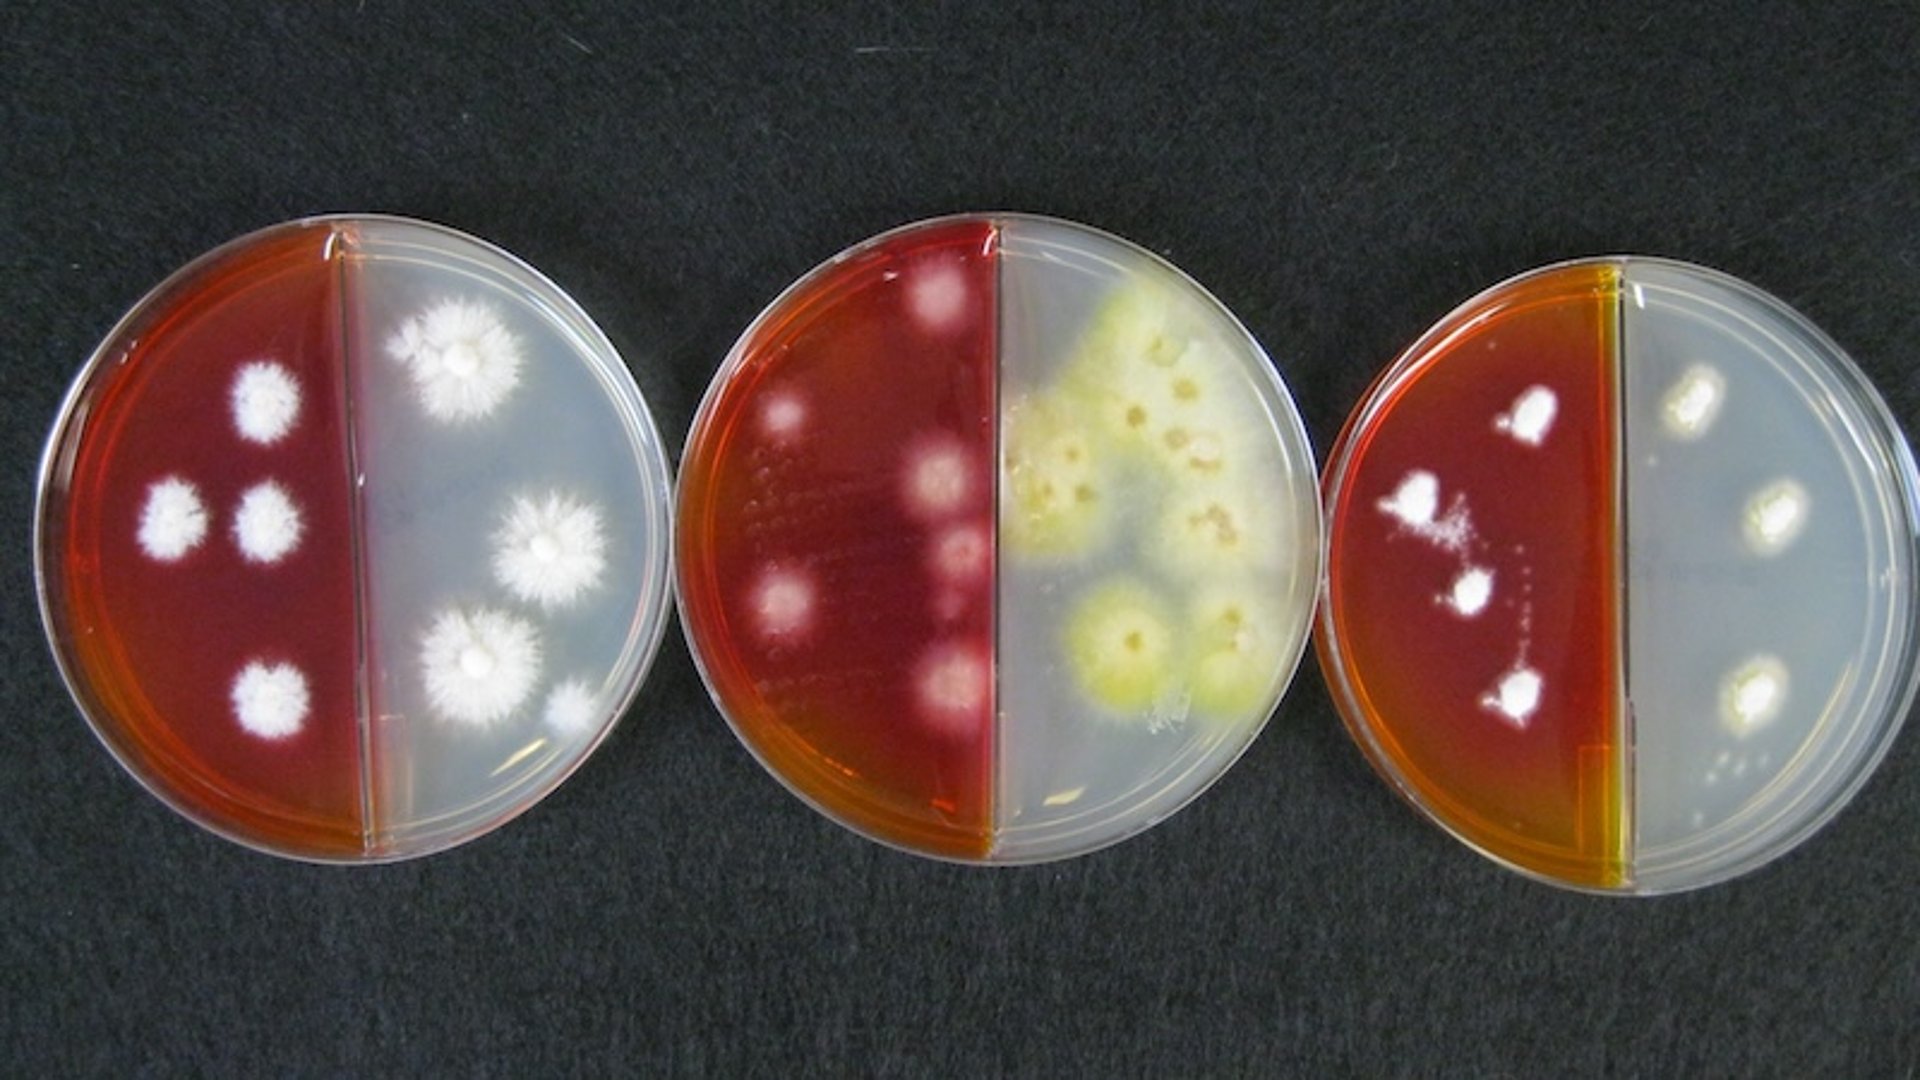
Comparación de la morfología macroscópica de colonias, patógenos comunes

Comparación de la morfología macroscópica de colonias, patógenos comunes
Comparación directa de Nannizzia gypsea (izquierda), Microsporum canis (centro) y Trichophyton spp. (derecha). Cada uno de los patógenos se inoculó en placas divididas con medio de cultivo para dermatofitos (DTM) y agar dextrosa Sabouraud. Los medios DTM alteran ligeramente la morfología macroscópica de la colonia de los patógenos; el crecimiento clásico se ve mejor en el agar Sabouraud. El crecimiento de Trichophyton es más lento que el de las otras dos especies.
Cortesía de la Dra. Karen A. Moriello.
En estos temas